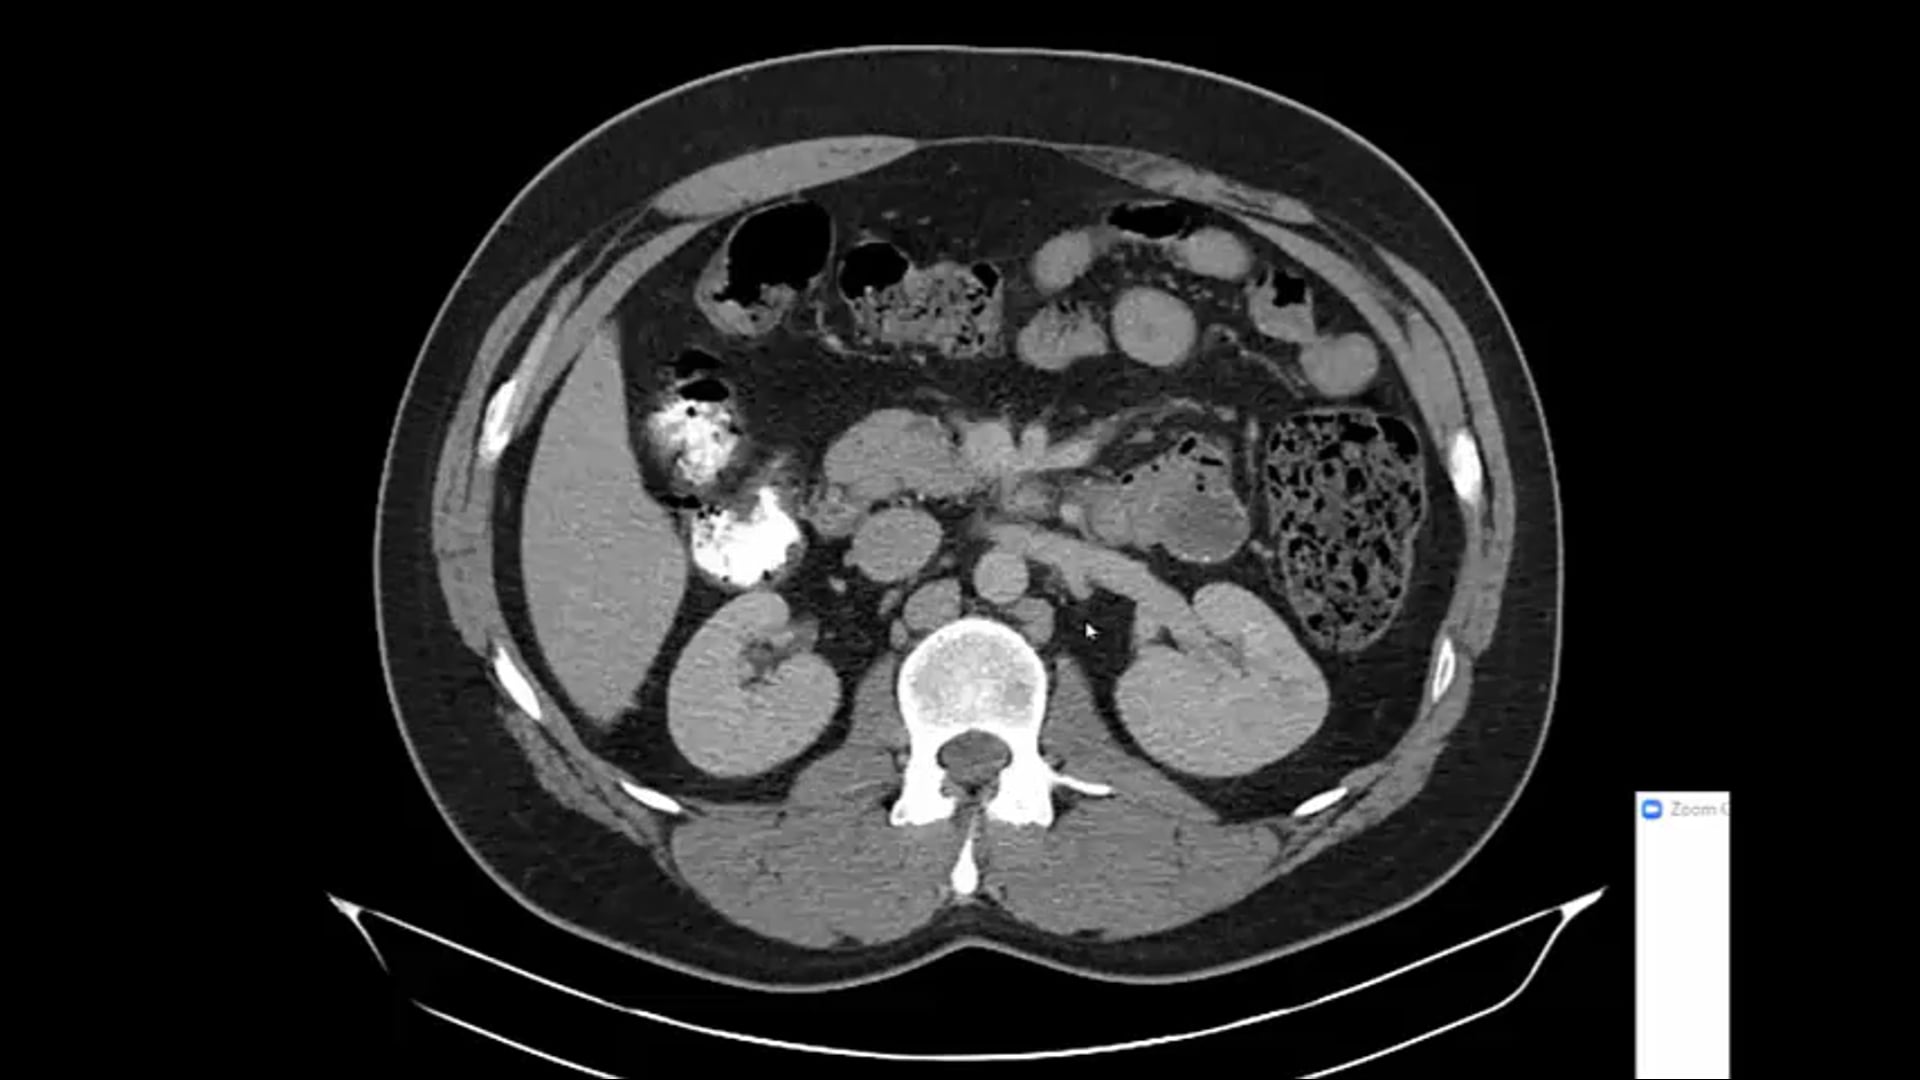
02/16/21 - Dr. Howard Sandler - Radiation Oncology - GU US

-
02/25/21 - Dr. Ronald Chen - Radiation Oncology - GU US
Renal cell CA, recurrent renal cancer, kidney mass, SBRT, small bowel dose constraints, bladder management during treatment, boost dose,
-
02/16/21 - Dr. Howard Sandler - Radiation Oncology - GU US
Stage II seminoma, testicular tumor, second malignancies, BEP chemotherapy, PSA, hypofractionation,
-
01/30 - Dr. Ronald Chen - Radiation Oncology - GU US
Stage IV prostate, tissue sparing, discordant PSA and biopsy, Gleason score, treatment, margins for SBRT, patient selection,
-
10/13/20 - Dr. Howard Sandler - Radiation Oncology - GU US
Prostate cancer, mesenteric disease, palliative care, muscle invasive bladder carcinoma, bladder mass, bladder preservation, Gleason 3 + 3
-
09/01/20 - Dr. Howard Sandler - Radiation Oncology - GU US
Pro PSMA trial looking at utility of PSMA scan for initial staging for high risk prostate cancer, metastatic disease, PSMA, pelvic nodal fields, long term outcomes
-
01/19/21 - Dr. Howard Sandler - Radiation Oncology - GU US
ADT timing, duration of ADT in high risk patients, dementia and alzheimer's risk, ADT outcome, toxicity, atlas study, biochemical relapse
-
07/23/20 - Dr. Ronald Chen - Radiation Oncology - GU US
Gleason 9 and Gleason 10 adenocarcinoma, rectal wall invasion, prostate active surveillance guidelines, Polaris test, PSA frequency, core volumes
-
09/24/20 - Dr. Ronald Chen - Radiation Oncology - GU US
IB seminoma, recurrent seminoma, salvage therapy, prostate, external beam and brachytherapy, spaceoar, bladder preservation, Ca of bladder
-
06/09/20 - Dr. Howard Sandler - Radiation Oncology - GU US
Nodes, radiotherapy, and prostate cancer, elective nodal radiation, short term ADT, imaging with PET, pelvic nodal radiation, prostate adenocarcinoma,
-
05/28/20 - Dr. Ronald Chen - Radiation Oncology - GU US
prostate adenocarcinoma, Gleason 4+4, dose, long term outcomes, ADT, GETUG-01, pelvic lymph node treatment fields, adenocarcinoma of the prostate, prostate radiation
-
04/07/20 - Dr. Howard Sandler - Radiation Oncology - GU US
High risk prostate cancer, prostate acing adenocarcinoma, bladder invasion, systemic therapy, ADT, rectal invasion, germline testing, BPH
-
03/26/20 - Dr. Ronald Chen - Radiation Oncology - GU US
Prostate cancer, Gleason 9, stage IV, treatment volume, femoral lesion, muscle invasive carcinoma, metastatic bladder cancer, oligometastatic disease,
-
03/03/20 - Dr. Howard Sandler - Radiation Oncology - GU US
Adenocarcinoma, RT fields, watchful waiting, axumin PET timing, patient management, local salvage therapy
-
09/25/19 - Dr. Ronald Chen - Radiation Oncology - GU US
GU ASTRO trials, prostate salvage treatment, treatment duration, ADT, adrenal carcinoma, treatment near the bowel
-
03/20/19 - Dr. Ronald Chen - Radiation Oncology - GU US
Prostate ca, DVH, treatment near bowel, DVH, post-prostectomy radiation, urinary incontinence, ADT in salvage therapy, PSA, salvage radiation
-
02/11/19 - Dr. Howard Sandler - Radiation Oncology - GU US
NRG Oncology, genomic classification, managing high risk patients, long term ADT, pelvic nodal radiation, treatment intensification, adjuvant vs. early salvage,
-
11/28/18 - Dr. Ronald Chen - Radiation Oncology - GU US
advanced prostate cancer, perirectal lymph nodes, seminal vesicle and prostate dose, bone mets, immune response, toxicity, metastatic sites
-
04/20/21 - Dr. Howard Sandler - Radiation Oncology - GU
-
05/11/21 - Dr. Howard Sandler - Radiation Oncology - GU
High risk prostate with castration, castration resistant, axumin pet scan, imaging trials, PSMA for initial staging, axumin vs PSMA, intraductal prostate carcinomas, prostate screening
-
05/27/2021 - Dr. Ronald Chen - Radiation Oncology - GU
Unfavorable intermediate risk prostate cancer, doubling time of 10.4 months, RT proctitis, SBRT, treatment,
-
06/08/2021 - Dr. Howard Sandler - Radiation Oncology - GU
Revolutionary vs. Evolutionary: adjuvant vs neoadjuvant ADT, research in PSMA technology, radiation for oligometastatic prostate cancer
-
06/24/2021 - Dr. Ronald Chen - Radiation Oncology - GU
oral agent vs. injection HERO trial, timing of RT, IMRT radiotherapy, salvage radiation, dose, ADT tradeoffs, prostate ca
-
07/13/2021 - Dr. Howard Sandler - Radiation Oncology - US GU
Postprostatectomy salvage radiotherapy, ADT and SBRT, seminal vesicle invasion, seminal vesicle MRI readings, nodal radiation
-
07/29/2021 - Dr. Ronald Chen - Radiation Oncology - US GU